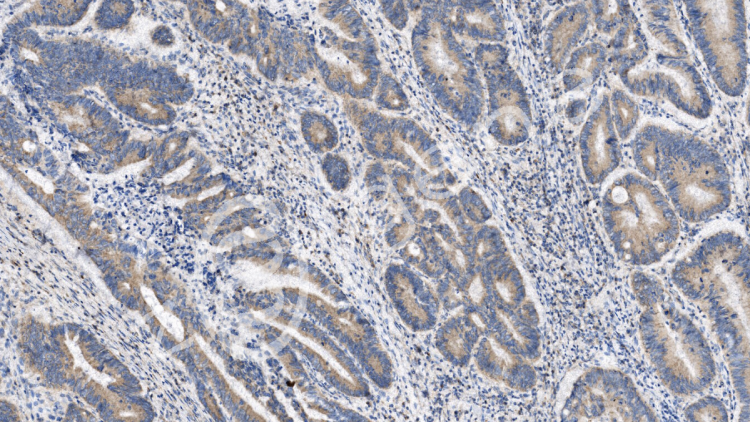
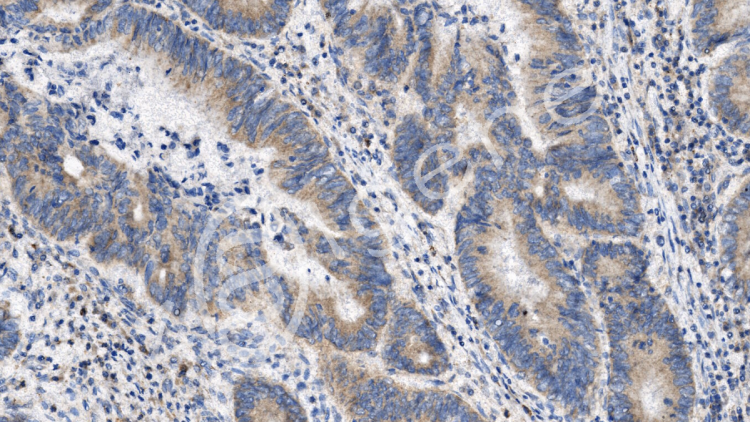

普通光學顯微鏡用于生物研究,其作用主要是將觀察的標本放大,連接CCD后可以將觀察的視野保存圖片形式,以便留存和分析。
載基白光拍照可接收:石蠟切片、細胞爬片、冰凍切片等(切片盒保存運輸)。
結果交付:3個視野,2個倍數,6張,常規同視野下200×3、400×3。默認圖片不加標尺,需要請在交接單上注明。也可后期在圖片的基礎上加;如無拍照要求,即按常見的部位拍,例如:肝中央靜脈、腦皮層海馬、腎小球等,特殊染色以及免疫組化陽性部位。特殊要求請提前說明。
病理檢測

182 5914 9342
fz_zolgene@163.com
免疫組化(IHC)